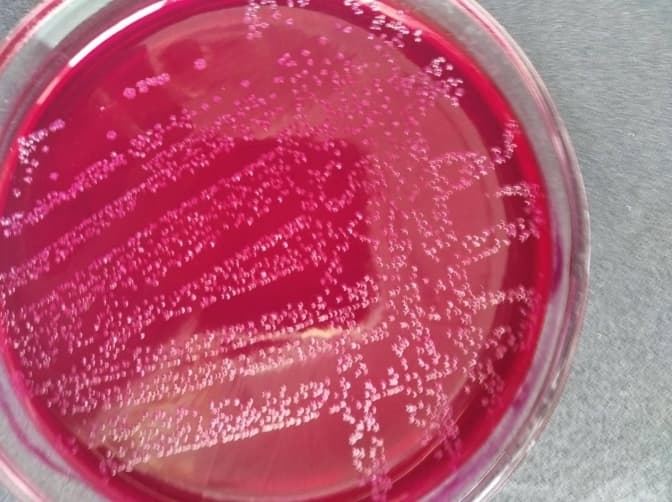
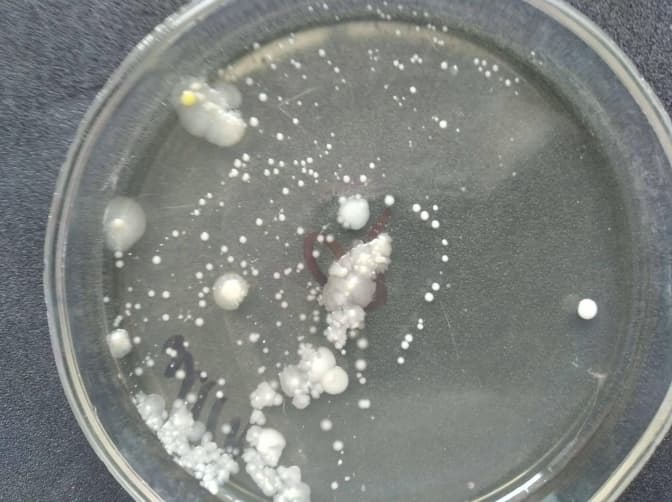

Леся Дзіняцька, донька якої на початку лютого отруїлася соком, всередині якого були цвіль та пліснява, так і не змогла зробити аналізи вмісту ні у Львові, ні в Яворові. Обдзвонивши ледь не усіх, лабораторне дослідження їй погодилися виконати аж в одній з лабораторій Чернівців. Про це Тvoemisto.tv повідомила сама Леся Дзвіняцька.
Читайте також: Сім кіл пекла. Мама дівчинки, яка отруїлася соком, досі не може добитися справедливості

«Мені все ж вдалося зробити аналіз цієї гидоти та паралельно аналізи дитини. Щоправда, не у львівських чи яворівських лабораторіях, бо там мені всюди відмовляли, а аж у Чернівцях, зокрема, на кафедрі мікробіології та вірусології», – каже Леся Дзвіняцька.
За її словами, за аналіз жінка заплатила 650 грн, але врешті з'ясувала, що саме вміст зі соку нашкодив дитині і поклав її на лікарняне ліжко. При чому, доньку продовжують лікувати.
«У пачці з-під соку Сандора висіяли цвілеві гриби в дуже великій кількості. Те ж саме виділили і в кишківнику доньки. Це означає, що дана гидота нашкодила дитині. За словами лікарки, якщо б моя дитина була алергетиком чи мала інші супутні захворювання, все б могло закінчитися трагічніше. Зараз донька продовжує лікування, оскільки, виявляється, той грибок досі знаходиться в її організмі», – веде далі жінка.
Читайте також: На Львівщині дитина отруїлася соком з пліснявою

Чому Лесі Дзвіняцькій довелося їхати аж у Чернівці, подивувалися в самій лабораторії. Щоправда, після нашого розголосу, два дні тому представники Держпродспоживслужби зателефонували їй і таки запропонували зробити дослідження, та жінка відмовилася, адже питання вже вирішила самостійно.
«Я витратила купу часу, нервів і коштів, аби дізнатися, що саме потрапило в організм моєї дитини. Але я це зробила. І я не хочу, аби ще хтось постраждав», – додала вона.
Нагадаємо, 4 лютого, у місті Новояворівську, що неподалік Львова, семирічна дитина випила сік від фірми «Sandora», пакетик якого був увесь в плісняві та цвіллі. Дівчинці відразу стало погано, її госпіталізували у лікарню. Що саме стало причиною отруєння жінка довгий час не могла дізнатися, адже у Держпродспоживслужбі вказали, що зробити аналіз не можуть і порадили звернутися до приватних лабораторій. Проте і там їй відмовили.
Ольга Шведа